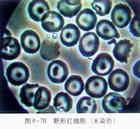
血紅蛋白D病
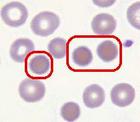
血紅蛋白D病

概述
血紅蛋白D實際上包括多種異常血紅蛋白,字母D表示鹼性pH電泳時伴有H
 賴氨酸
賴氨酸 谷氨酸
谷氨酸流行病學:
血紅蛋白D是1951年Itano首次發現的,血紅蛋白D病主要見於印度、巴基斯坦和伊朗。已如前述,凡鹼性pH的電泳位置與HbS相同而溶解度正常的異常血紅蛋白統稱為HbD,因而HbD包括許多不同性質的血紅蛋白,其中以印度北部的Punjab地區最常見,稱為HbD Punjab,在當地發病率高達3% 在我國HbD以北方較多見,內蒙古 新疆、北京、河南、甘肅、四川、黑龍江等地的漢、蒙、回、維吾爾、哈薩克等民族中都曾有HbD發現 。
病因
化學分析表明,HbD包括多種不同性質的血紅蛋白,現已發現至少1
 Boc-L-賴氨酸
Boc-L-賴氨酸 谷氨酸分子式模型
谷氨酸分子式模型 谷氨酸分子式
谷氨酸分子式發病機制:
血紅蛋白D病是由於珠蛋白基因發生點突變,β-珠蛋白鏈上某種胺基酸被另一胺基酸取代,使血紅蛋白的性質和功能發生變化而引起的疾病。血紅蛋白C是β-珠蛋白基因發生突變,使β-珠蛋白鏈第6位上的谷氨酸被賴氨酸取代的異常血紅蛋白。
症狀
臨床表現:
病狀和體徵 HbD Punjab純合子 可有輕度溶血性貧血,輕度或中度脾大,但大多沒有症狀和體徵。
診斷:
根據臨床表現,特別是血紅蛋白電泳做出診斷。
鑑別診斷:
在鹼性pH電泳的位置與HbS相同,應和鐮形細胞性狀鑑別 用pH 6.2澱粉電泳時HbD和HbA的速度相同而與HbS分開 可供鑑別。另外,HbD溶解度正常,鐮變實驗陰性也可區別於鐮狀細胞性狀。
檢查
實驗室檢查:
1.外周血 HbD純合子可有輕度溶血性貧血的實驗室檢查結果,血片中可見到靶形紅細胞和球形紅細胞。HbD雜合子血紅蛋白正常 可見少量靶形紅細胞。
2.血紅蛋白電泳 示HbD占血紅蛋白的95%以上。血紅蛋白電泳示HbD占血紅蛋白的35%~50%。
靶形紅細胞
靶形紅細胞 球形紅細胞
球形紅細胞相關檢查:
球形紅細胞
血紅蛋白
血紅蛋白電泳
靶形紅細胞
治療
維生素C 150~300mg/天,口服,尚無特殊治療方法,大多無需臨床治療

